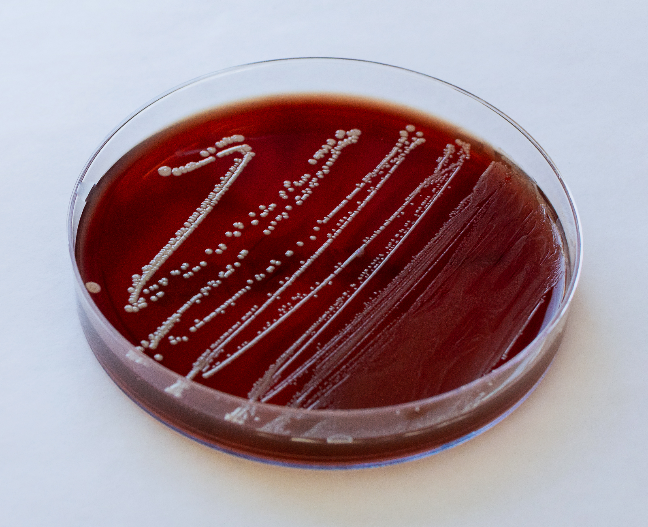
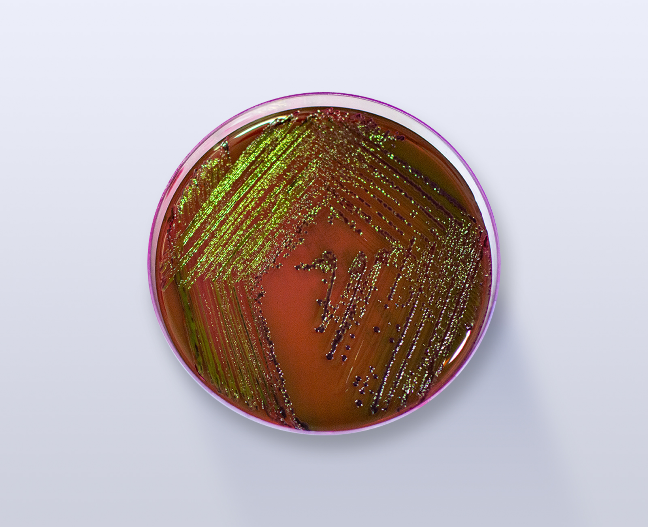

Olá pessoal, tudo bem com vocês?
Você já parou para pensar no porquê que os microrganismos precisam de meios de culturas específicos para crescerem? No blog de hoje vamos falar sobre os meios de cultura, de que são feitos e como atuam.
Vamos lá?
Todo microrganismo precisa de três itens indispensáveis para sua sobrevivência, são eles: nutrientes essenciais, temperatura ótima de crescimento e atmosfera adequada. Sempre que precisamos fazer o estudo de suas características ou cultivá-los em geral, precisamos ter certeza que estamos fornecendo um ambiente propício para seu crescimento ideal!1
Os meios de cultura surgiram em meados do século 19, quando começaram a se fazer estudos sobre maneiras de propriamente podermos observar microrganismos patogênicos ou não de uma forma mais viável para aquele que as manuseava. Eram uma maneira prática para o fornecimento dos nutrientes essenciais para aquela bactéria, fungo ou levedura, com uma formulação pronta e replicável2.

O primeiro que se tem registro foi desenvolvido em 1860, por Louis Pasteur, através de uma mistura de levedura, açúcar e sais de amônia. Foi só em 1881 que se implementou o uso do ágar, quando W. Hesse utilizou parte do que sua esposa havia cozinhado para ser o agente solidificante. É o ágar que confere o aspecto gelatinoso que conhecemos alguns meios de cultura por terem. Seis anos depois, em 1887, desenvolveram a placa de Petri, cujo modelo continua sendo aplicado até os dias atuais. Após isso, os estudos voltaram-se a aprimorar as fórmulas, e foi quando começaram a nascer os inúmeros tipos de meios que conhecemos hoje.2,3
Como são classificados?
É muito importante que no momento de cultivar seu microrganismo, você escolha o meio mais propício para aquilo que você deseja. Dessa forma, os meios foram classificados de acordo com seu conteúdo químico, sua consistência e seu uso em laboratório.
O conteúdo químico divide os meios em dois: os quimicamente definidos e os quimicamentes indefinidos.
Os quimicamente definidos são aqueles que já possuem quantidades fixas e já determinadas de cada aditivo a ser feito, que serão adicionados à água destilada! É um exemplo o Ágar Cled (Figura 2), ou ágares específicos para a Escherichia coli. Já os meios quimicamente indefinidos ou complexos são aqueles que vão necessitar de alguma adição, e por isso, eles não possuem uma composição química exata. Temos como exemplo o Ágar Sangue (Figura 3), em que deve ser adicionado sangue de carneiro. Alguns meios podem precisar de adição de leite, soro, casca de ovo, entre outros. Por isso, é importante ler e seguir atentamente as instruções do fornecedor, para que o meio possa atingir sua finalidade.1

De acordo com a consistência, os meios serão divididos em: sólidos, semi-sólidos e líquidos.
Os meios sólidos possuem adição de Ágar que varia de 1 a 1,5%, permitindo que formem um meio menos gelatinoso e mais sólido (Figura 4). Nele, conseguimos observar os microrganismos se desenvolvendo em seu pequeno conglomerado, uma massa de formato variável, chamada de colônia. Como o meio é mais sólido, eles ficam imóveis e a observação de características como a mudança de cor, o formato, as bordas e produção de qualquer elevação na superfície do meio fica mais perceptível. Esses meios são usualmente colocados em placas de Petri, mas também podem ser colocados em tubos, formando um bisel.
Os meios semi-sólidos já terão uma menor acreção de Ágar, de 0,05% a 0,5%, permitindo que ele adquira uma textura similar a de gel de cabelo (Figura 5). Costumam ser mais utilizados para testes de motilidade, ou seja, quando precisamos observar se o microrganismo se movimenta ou não. Se tivéssemos um meio sólido, a bactéria ficaria muito imóvel para podermos observar seu movimento, mas também, se tivéssemos em um meio líquido, não poderiamos dizer com exatidão se houve movimento. Através desse meio semi-sólido, é possível observar o “trajeto” do microrganismo, facilitando para quem necessita determinar se existe motilidade ou não.

Por fim, os meios líquidos não possuem acresção de Ágar, sendo normalmente chamados de “caldos” (Figura 6). Usualmente, eles permitem o crescimento indiscriminado dos microrganismos, formando uma turbidez no líquido. É através dessa turbidez que sabemos que houve a própria colonização do caldo. Esse tipo de meio é utilizado para transporte de microrganismos e para justamente fazer o crescimento exponencial de alguma bactéria, fungo ou levedura que se deseje observar. Alguns microrganismos, chamados de fastidiosos, que são aqueles que demandam muitos nutrientes e são de difícil crescimento, costumam ser crescidos nos caldos primeiro para depois serem propriamente semeados em meios sólidos, uma vez que nos meios líquidos temos muito mais facilidade de fazer eles se desenvolverem.

Quanto ao uso em laboratório, os meios podem ser: enriquecidos, de enriquecimento, seletivos, diferenciais, indicadores, de transporte e de manutenção.
O meio enriquecido é aquele utilizado para permitir o crescimento da maioria dos organismos, sem nutrientes adicionais específicos!3 Usualmente, é utilizado para o crescimento de alguns microrganismos não-fastidiosos, e alguns podem até crescer microrganismos fastidiosos. Um exemplo seria o Ágar Chocolate, que por possuir em seus componentes um acréscimo de sangue hemolisado (sangue em que as hemácias foram destruídas), permite o crescimento de gêneros de bactérias como Haemophilus spp. e Neisseria spp. Entretanto, não confunda com meio de enriquecimento! Os meios de enriquecimento costumam normalmente serem caldos, utilizados para “ressuscitar” microrganismos que se encontram num desenvolvimento pobre ou que estão morrendo, de maneira a viabilizá-las novamente. Um exemplo seria o Caldo BHI, altamente nutritivo e que permite o crescimento indiscriminado de microrganismos.
Os meios seletivos são aqueles utilizados quando se deseja isolar microrganismos, possuindo substâncias em sua composição que irão inibir o crescimento de outros patógenos. Um exemplo é o Ágar MacConkey! Ele é um meio seletivo para microrganismos gram-negativos. Dessa forma, microrganismos gram-positivos, mesmo quando inoculados no meio, não apresentam crescimento por conta da presença do cristal violeta e do ácido biliar. Alguns meios podem ser tanto seletivos quanto diferenciais. Eles são diferenciais quando possuem alguns ingredientes que irão permitir que um microrganismo seja diferenciado de outro, como o próprio Ágar MacConkey. Além de ser seletivo, ele é diferencial por possuir em sua composição a adição de lactose e de um indicador de pH. Quando uma bactéria faz a fermentação da lactose, transformando-a em ácido, produzem colônias vermelhas ou rosadas, o que permite a identificação dos organismos fermentadores da lactose. 3,4
Os meios indicadores são aqueles utilizados para fazer as provas bioquímicas, que auxiliam na identificação de microrganismos. Observe que os meios indicadores também são diferenciais, entretanto, essa diferença na classificação surge pois enquanto alguns meios diferenciais podem ser utilizados para o crescimento dos microrganismos, os indicadores são utilizados estritamente para observação da prova desejada. São exemplos o Ágar Citrato de Simmons, que permite a diferenciação entre bactérias citrato positivo e citrato negativo5; o Ágar DNAse, que permite a diferenciação entre bactérias DNAse negativa e DNAse positiva6; e o Ágar TSI, um ágar muito versátil que permite a identificação da fermentação da glicose, da sacarose e da lactose, a observação da formação de gás de glicose ou não, e a formação de H2S, um produto da fermentação feita por algumas bactérias como as Salmonella spp.7
Por fim, os meios de transporte e os meios de manutenção são utilizados para fazer o transporte de amostras ou sua acomodação durante um curto período de tempo, de forma a manter os microrganismos ali contidos viáveis até sua utilização. São exemplos os meios Cary-Blair e o meio Stuart.
Referências
1 MADIGAN, Michael et al. Microbiologia de Brock. 14ª ed. Porto Alegre: Artmed, 2016.
2 Power, David A.; Mary Jo Zimbro. 2003. Difco & BBL manual: manual of microbiological culture media. Sparks, MD: Difco Laboratories, Division of Becton Dickinson and Co.
3 MURRAY, Patrick. Microbiologia Médica. Rio de Janeiro: Grupo GEN, 2017.
4 BLACK, Jacquelyn G.; BLACK, Laura J.. Microbiologia: Fundamentos e Perspectivas. Rio de Janeiro: Grupo GEN, 2021.
5 LABORCLIN. Citrato de Simmons. Disponível em: https://www.laborclin.com.br/wp-content/uploads/2019/05/510014-CITRATO-SIMMONS-AGAR-3mL-TB13X1.pdf. Acesso em: 9 nov. 2021.
6 LABORCLIN. Ágar DNASE. Disponível em: https://www.laborclin.com.br/wp-content/uploads/2019/06/Agar_DNASE_540219.pdf. Acesso em: 8 nov. 2021.
7 LABORCLIN. TSI – Triple Sugar Iron. Disponível em: https://www.laborclin.com.br/wp-content/uploads/2019/06/TSI_Triple_Sugar_Iron_510111.pdf. Acesso em: 9 nov. 2021.
8 PLASTLABOR. Placa Ágar Sangue Carneiro com Azida. Disponível em: https://plastlabor.com.br/produtos/pl-agar-sangue-carneiro-c-azida-90mm/. Acesso em 10 nov. 2021.
9 PLASTLABOR. Placa Ágar Cled (Brolacin). Disponível em: https://plastlabor.com.br/produtos/pl-agar-cled-brolacin-90mm/. Acesso 10 nov. 2021.
10 PLASTLABOR. Placa Ágar Superpolimixina. Disponível em: https://plastlabor.com.br/produtos/placa-agar-superpolimixina/. Acesso 11 nov. 2021.
11 INTERLAB. MIO (Meio de). Disponível em: https://www.interlabdist.com.br/produto/mio-meio-de/. Acesso 10. nov 2021.
